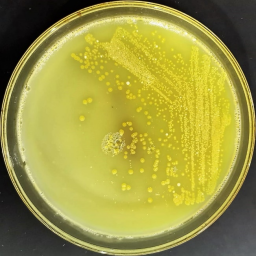

Development of a Sustainable Bio-production Strategy for Actinomycin X2 Ref. No. SSTCRC071
Title:
Development of a Sustainable Bio-production Strategy for Actinomycin X2 Using a Novel Streptomyces sp. Strain UKAQ_23: Heterologous Expression in Escherichia coli, Toxicity Reduction, and Evaluation for Human Therapeutic Applications in Antimicrobial, Antiviral, Antiprotozoal, and Anticancer Treatments
Background:
Actinomycins are a class of secondary metabolites produced by various Streptomyces species that exhibit remarkable therapeutic potential in diverse areas such as antimicrobial, antiviral, antiprotozoal, and anticancer treatments.
Among them, Actinomycin X2 has shown exceptional efficacy against a wide range of diseases. However, the limited availability of Actinomycin X2 and its associated toxicity concerns have hindered its widespread clinical use. Therefore, the development of a sustainable bio-production strategy for Actinomycin X2 is of utmost importance to meet the increasing demand for this valuable compound.
In this research proposal, we aim to establish a sustainable bio-production strategy for Actinomycin X2 by utilizing a novel Streptomyces sp. strain UKAQ_23 (Figure 1). This strain has been identified as a promising producer of Actinomycin X2, offering a potential solution to the supply limitations. By harnessing the unique capabilities of strain UKAQ_23, we aim to optimize Actinomycin X2 (Figure 2) production and overcome the challenges associated with its limited availability.
Figure 1. Novel Streptomyces sp. strain UKAQ_23.

Figure 2. Actinomycin (X2 +D) complex produced by novel Streptomyces sp. strain UKAQ_23.
To enhance the efficiency of Actinomycin X2 production, we propose the implementation of heterologous expression in Escherichia coli. This approach allows for the transfer and expression of Actinomycin X2 biosynthetic gene clusters from strain UKAQ_23 into a more easily manipulated and scalable host system. By optimizing the expression conditions in Escherichia coli, we anticipate increased production yields and improved downstream processing of Actinomycin X2.
Furthermore, the toxic effects associated with Actinomycin X2 pose significant hurdles to its therapeutic applications. Therefore, an integral part of this research proposal involves the reduction of Actinomycin X2 toxicity while maintaining its therapeutic efficacy. Through comprehensive toxicity evaluations using in vitro and in vivo models, we aim to identify strategies to mitigate its adverse effects and enhance its safety profile.
Finally, we will evaluate the potential of Actinomycin X2 for human therapeutic applications in antimicrobial, antiviral, antiprotozoal, and anticancer treatments. This assessment will encompass a range of studies, including the investigation of its antimicrobial and antiviral activities against clinically relevant pathogens, evaluation of its efficacy in combating protozoal infections, and exploration of its anticancer properties against various cancer cell lines. Additionally, we will assess the safety, pharmacokinetic properties, and overall therapeutic potential of Actinomycin X2 for human use.
In conclusion, this research proposal aims to develop a sustainable bio-production strategy for Actinomycin X2 using a novel Streptomyces sp. strain UKAQ_23. Through the implementation of heterologous expression in Escherichia coli, toxicity reduction strategies, and evaluation for human therapeutic applications, we seek to overcome the limitations associated with Actinomycin X2 availability and toxicity. The successful realization of this research proposal will provide a foundation for the development of Actinomycin X2 as a valuable therapeutic agent for various diseases, benefiting the field of medicine and improving patient outcomes.
1. Aim:
l To establish a sustainable bio-production strategy for Actinomycin X2 by leveraging the unique characteristics of the novel Streptomyces sp. strain UKAQ_23.
Objectives:
l Isolate and characterize the Streptomyces sp. strain UKAQ_23, evaluating its potential for Actinomycin X2 production.
l Optimize the culture conditions and fermentation parameters for enhanced Actinomycin X2 yield.
l Develop a scalable and environmentally sustainable production process for Actinomycin X2 using strain UKAQ_23.
2. Aim:
l To explore the heterologous expression of Actinomycin X2 in Escherichia coli to improve production efficiency and facilitate downstream processing.
Objectives:
l Clone and express the Actinomycin X2 biosynthetic gene cluster from Streptomyces sp. strain UKAQ_23 into Escherichia coli.
l Optimize the expression system to enhance Actinomycin X2 production in Escherichia coli.
l Compare the production efficiency and product quality of Actinomycin X2 in Escherichia coli with the native production in Streptomyces sp. strain UKAQ_23.
3. Aim:
l To reduce the toxicity of Actinomycin X2 and assess its suitability for human therapeutic applications in antimicrobial, antiviral, antiprotozoal, and anticancer treatments.
Objectives:
l Evaluate the toxicity profile of Actinomycin X2 using in vitro and in vivo models.
l Develop strategies to reduce the toxicity of Actinomycin X2 while preserving its therapeutic efficacy.
l Investigate the antimicrobial, antiviral, antiprotozoal, and anticancer properties of Actinomycin X2 using relevant assays and models.
l Assess the potential of Actinomycin X2 for human therapeutic applications, including determining its safety, efficacy, and pharmacokinetic properties.
Research Progress:
1. Isolation and Characterization of Streptomyces sp. strain UKAQ_23 = Done
2. Whole-genome sequencing and genomic analysis of Streptomyces sp. strain UKAQ_23 = Done
3. Development of E. coli strain heterologously expressing the gene(s) for actinomycin X2 production = Pending
4. Characterization of E. coli actinomycin X2 overproducing strain = Pending
5. Production and Process optimization to produce actinomycin X2 from genetically modified E. coli = Pending
6. Isolation and purification of actinomycin X2 from genetically modified E. coli = Pending
7. Characterization of actinomycin X2 from genetically modified E. coli = Pending
8. Bio-evaluation of actinomycin X2 from genetically modified E. coli = Pending
9. Toxicity reduction and stability evaluations of actinomycin X2 = Pending
10. Evaluation of future applications of actinomycin X2 in various industries = Pending
Cooperation Needs:
l Laboratory facilities to conduct my experiments and research.
l Willing to relocate to a location where these facilities are available.
l Seeking a suitable environment where I can dedicate my full efforts to generate novel products with commercial value.
Benefits:
l The development of novel strategies to produce Actinomycin X2 represents a pioneering approach in the field of bio-production and therapeutic applications. This study aims to address the challenges associated with Actinomycin X2 availability and toxicity by proposing a unique and innovative bio-production strategy.
l To the best of our knowledge, this is the first study to investigate the sustainable bio-production of Actinomycin X2 using a novel Streptomyces sp. strain UKAQ_23. The utilization of this strain, which has demonstrated promising potential for Actinomycin X2 production, presents a new and exciting avenue for overcoming the limited availability of this valuable compound.
l Furthermore, our study employs a heterologous expression system in Escherichia coli, a groundbreaking approach that has not been previously explored for Actinomycin X2 production. This innovative strategy allows for the transfer and expression of Actinomycin X2 biosynthetic gene clusters from strain UKAQ_23 into a more efficient and scalable host system. By leveraging the advantages of Escherichia coli, we anticipate significant improvements in Actinomycin X2 production efficiency and downstream processing.
l In addition to addressing production challenges, this study pioneers the exploration of toxicity reduction strategies for Actinomycin X2. The assessment and mitigation of Actinomycin X2 toxicity represent a crucial step towards its clinical applicability. By implementing comprehensive toxicity evaluations using advanced in vitro and in vivo models, we aim to develop novel approaches for minimizing the adverse effects associated with Actinomycin X2 while preserving its therapeutic efficacy.
l Moreover, this study represents a pioneering effort in evaluating the suitability of Actinomycin X2 for human therapeutic applications in antimicrobial, antiviral, antiprotozoal, and anticancer treatments. The comprehensive assessment of its pharmacological activities against clinically relevant pathogens, protozoal infections, and cancer cell lines provides valuable insights into its potential clinical utility. This novel evaluation aims to lay the foundation for the future development and translation of Actinomycin X2 as a powerful therapeutic agent in various medical fields.
l In summary, this study breaks new ground by proposing a sustainable bio-production strategy for Actinomycin X2 using a novel Streptomyces sp. strain UKAQ_23. The implementation of heterologous expression in Escherichia coli, the exploration of toxicity reduction strategies, and the evaluation for human therapeutic applications represent pioneering efforts in the field. By pioneering this novel approach, we aim to revolutionize the availability, toxicity profile, and therapeutic potential of Actinomycin X2, ultimately benefiting medical research and improving patient outcomes.
Outputs:
Minimum 2-3 high impact factor peer-reviewed original research articles.
1-2 US patents.
Other proposal:
l As an accomplished specialist in microbial biotechnology, I am actively seeking a challenging position as a scientist within a well-equipped laboratory that boasts state-of-the-art instruments and facilities dedicated to synthetic biology and analytical chemistry. My aim is to leverage my expertise and experience to spearhead innovative projects in microbiology and biotechnology, with the potential for successful commercialization.
l Access to a laboratory equipped with fundamental synthetic biology and microbial fermentation technology resources would provide me with the essential infrastructure to undertake cutting-edge research. By harnessing these facilities, I would have the opportunity to explore new frontiers in genetic and metabolic engineering, as well as optimize microbial cultivation techniques. These endeavors would enable the development of novel microbial strains with enhanced capabilities and the production of valuable bioproducts.
l The inclusion of ultramodern instruments associated with synthetic biology and analytical chemistry within the laboratory would greatly amplify the depth and breadth of my research capabilities. Advanced technologies such as DNA synthesis and sequencing, high-throughput screening platforms, next-generation sequencing, and mass spectrometry would empower me to engage in intricate molecular manipulations, analyze complex biological systems, and elucidate metabolic pathways. Ultimately, this would expedite research progress and lead to impactful scientific publications.
l Moreover, the prospect of working in a laboratory equipped with these cutting-edge resources holds the potential for generating intellectual property through patents. By capitalizing on innovative projects and discoveries, there is a substantial opportunity to develop commercially viable microbial-based products, processes, and technologies. The resulting intellectual property rights would not only safeguard my innovations but also facilitate collaborations, technology transfer, and licensing agreements, thereby fostering economic growth and financial gains.
In summary, my expertise in microbial biotechnology, coupled with the desire to work in a fully equipped laboratory, positions me to contribute significantly to the field. Given the opportunity to operate within a laboratory boasting ultramodern instruments related to synthetic biology and analytical chemistry, I am confident in my ability to undertake groundbreaking projects at the intersection of microbiology and biotechnology. The potential for commercialization and the ability to publish impactful research further underscore the value of securing such a position. I look forward to the chance to leverage these resources and make substantial contributions to both scientific knowledge and economic prosperity.